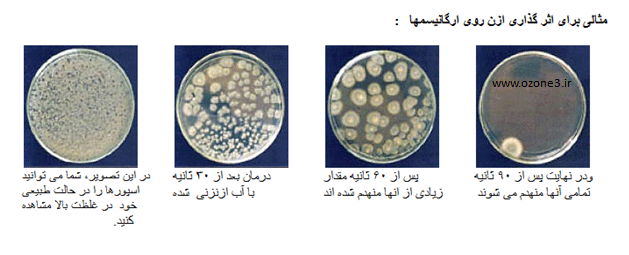

ضدعفونی مرغ، ماهی و گوشت قرمز
ضدعفونی مرغ، ماهی و گوشت قرمز
ضدعفونی مرغ، ماهی و گوشت قرمز
ضدعفونی مرغ، ماهی و گوشت قرمز
Tags ازن ازن اب اکسیژن اکسیژن فعال پوست حذف الاینده دستگاه سم زدایی دفع سموم روند شیمیایی ازن ژنراتور سبزیجات سم زدایی صنعت ازن ضدعفونی فعال کاربرد کاربردهای ازن گوشت ماهی مرغ هورمونی
استریل کردن با اکسیژن فعال روش بسیار موثر و مقرون به صرفه ای برای پاکسازی و ضدعفونی کردن …